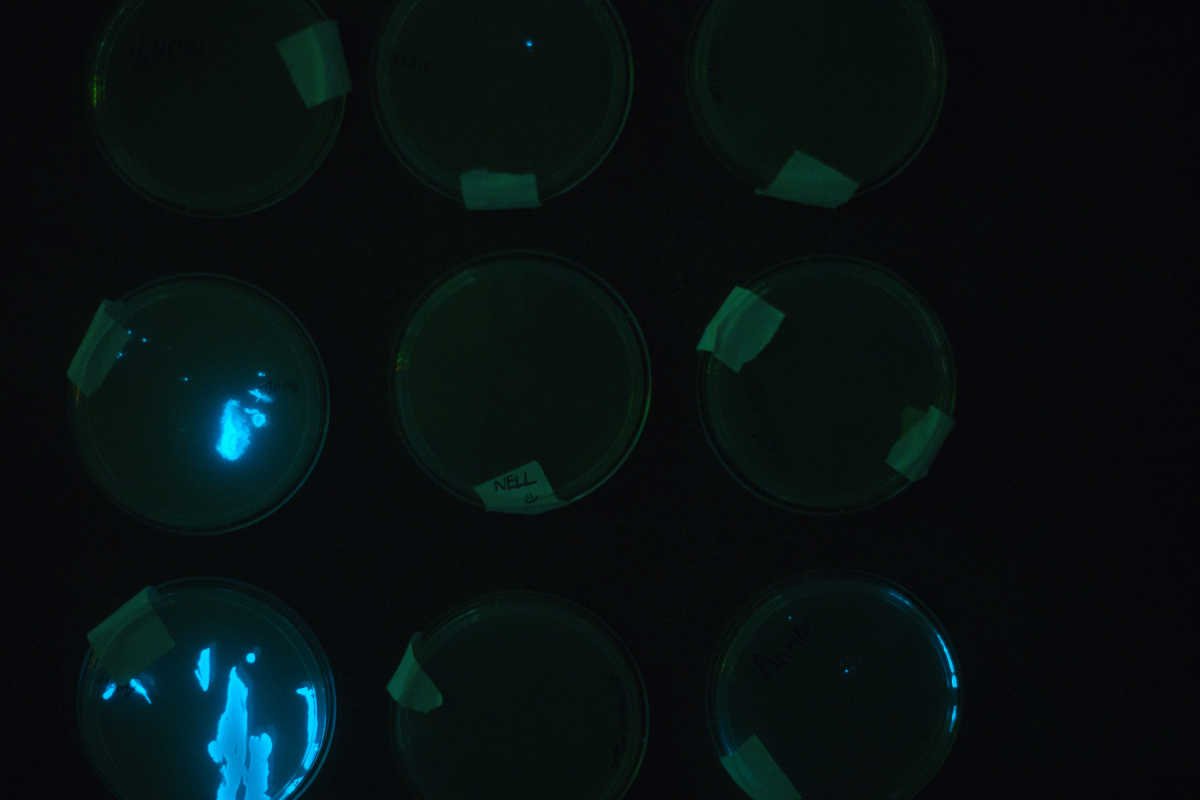
ScienceHackDayPDX tweet media
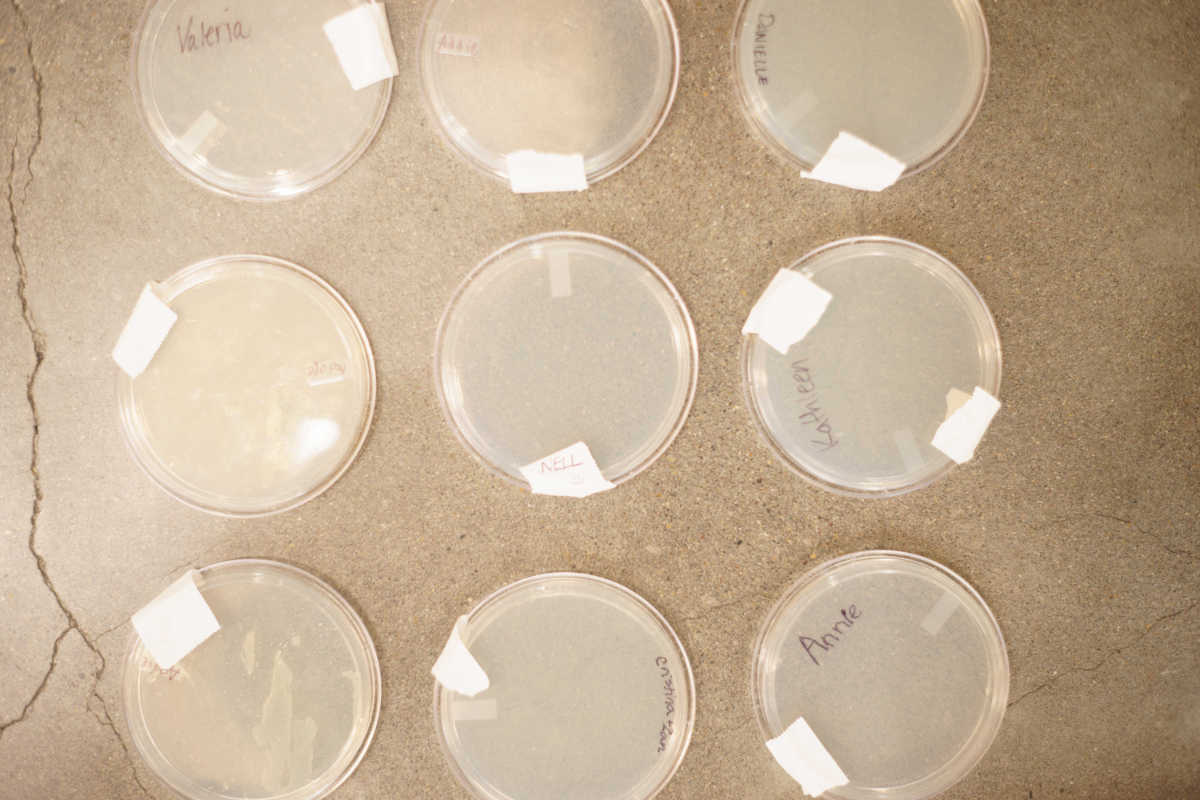
ScienceHackDayPDX tweet media

고정된 트윗

THANKS EVERYBODY! That's a wrap! ❤ Our science hackers, ❤ our sponsors & ❤ to the organizer team! Tweet your photos & ❤ @science_hackPDX
GIF
English
ScienceHackDayPDX
336 posts


@science_hackPDX
A free, all-ages event for making fun things with science in Portland, OR


Intel Northwest Science Expo Reduced Requirements For Judging - stemoregon.org/intel-northwes… #STEM @ORLearns